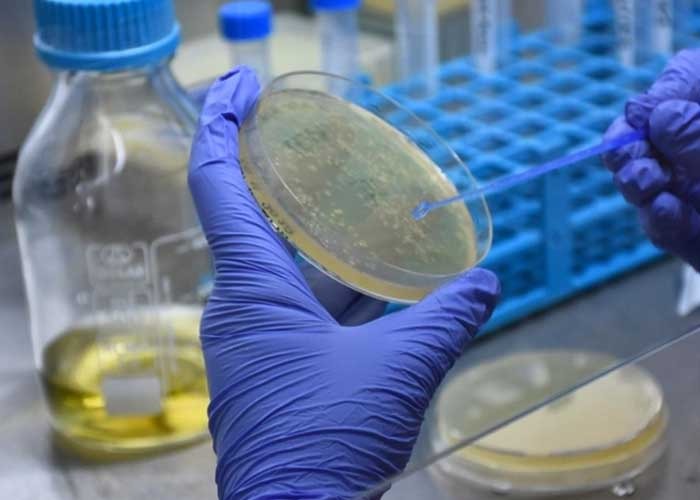

Ministerio del Poder Ciudadano para la Salud proyecto de vacunas para el COVID-19.
Actualmente están disponibles en el mercado y a través del mecanismo de compra anticipada de COVAX, cuatro vacunas con eficacia mayor del 90%.
Te puede interesar: Fumigación para acabar con molestos mosquitos en Laureles Norte
1. Vacuna de Pfizer-BioNTech con eficacia del 95%, pero su almacenamiento requiere temperatura de –70°C, que ameritaría un alto presupuesto para la cadena de frío.
2. Vacuna Moderna con eficacia de 94.5%, con almacenamiento de +2 a 8°C y congelación a -20°C, que es compatible con nuestra cadena de frío y requeriría compra de equipos de refrigeración para aumentar la capacidad de almacenamiento del nivel local.
3. Vacuna Sputnik V con eficacia de 91.4%, con almacenamiento de +2 a 8°C y congelación a -18°C, que es compatible con nuestra cadena de frío y requeriría compra de equipos de refrigeración para aumentar la capacidad de almacenamiento del nivel local.
#Nicaragua | Actualmente están disponibles en el mercado y a través del mecanismo de compra anticipada de COVAX, cuatro vacunas. https://t.co/Ef9fLQjWwn
— TN8 Nicaragua (@canaltn8) January 13, 2021
4. Vacuna de Oxford-AstraZeneca, con eficacia de 90%, con almacenamiento de +2 a 8°C y congelación a -18°C, que es compatible con nuestra cadena de frío y requeriría compra de equipos de refrigeración para aumentar la capacidad de almacenamiento del nivel local.
5. Covaxina (Bharat Biotech), vacuna de la India, propuesta por Mechnikov para su comercialización. Enviamos ya nota de aceptación de donación y de interés de compra.
En vista de esta situación el MINSA ha propuesto las siguientes cuatro vacunas para seguimiento de compra: Vacuna Sputnik, Vacuna Moderna, Vacuna Oxford–AstraZeneca, y Vacuna Covaxina, Vacuna de la India.
1. La Vacuna Sputnik, para proteger a 1,900,000 personas para un total de 3,800,000 dosis y un costo final de USD $49,967,250.70, que incluye las dosis de vacuna, costo de fletaje y seguro; así como, costo de insumos (jeringas, cajas de seguridad y algodón), más refrigeración.
2. Vacuna Moderna, para proteger a 750,000 personas para un total de 1,500,000 dosis y un costo final de USD $34,963,914.75, que incluye las dosis de vacuna, costo de fletaje y seguro; así como, costo de insumos (jeringas, cajas de seguridad y algodón), más refrigeración.
3. Vacuna Oxford-AstraZeneca para proteger a 1,081,900 personas para un total de 2,163,800 dosis y un costo final de USD $29,963,818.79, que incluye las dosis de vacuna, costo de fletaje y seguro; así como, costo de insumos (jeringas, cajas de seguridad y algodón), más refrigeración.
4. Covaxina (Bharat Biotech), vacuna de la India. Fue enviada nota de aceptación de donación y de interés de compra. Todavía no tenemos información de precios.
Con estos montos (1 al 3) protegemos a 3,731,900 personas equivalente al 55% de la población del País.
El Gobierno realiza gestiones adicionales para completar financiamiento y cubrir la vacunación de toda la población.